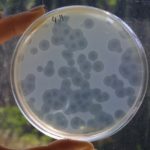

FIFA ka zbuluar këtë të mërkurë listën prej 10 futbollistësh kandidatë për fitimin e çmimit prestigjioz “Lojtari Më i Mirë i Vitit 2019”, bazuar në arritjet e tyre për periudhën 16 korrik 2018 – 19 korrik 2019.
Përzgjedhja e kandidatëve është bërë nga një panel ekspertësh në futbollin e meshkujve.
Fansat tani mund të votojnë në faqen e FIFA-s për të preferuarit e tyre për tre të parët. Zgjedhja e parë: 5 pikë, zgjedhja e dytë: 3 pikë dhe zgjedhja e tretë: 1 pikë. Vota e tifozëve do të ketë peshë të barabartë krahas votave të anëtarëve të tjerë kryesorë të komunitetit të futbollit, përkatësisht të gazetarëve, trajnerëve të ekipeve kombëtare dhe kapitenëve. Fituesit do të shpallen më 23 shtator në ceremoninë e “The Best FIFA Awards” që do të zhvillohet në Milano.
Kandidatët:
Cristiano Ronaldo: Ndihmoi Juventusit në fitimin e titullit si golashënuesi më i mirë i ekipit në të gjitha kompeticionet. Është votuar si lojtari më i vlefshëm i Serisë A. Ndihmoi Portugalinë të triumfonte në Nations League.
Frenkie Jong: Fitoi kampionatin dhe Kupën në Holandë. Arriti në gjysmëfinale të Championsit me Ajaxin. U votua futbollisti i sezonit në Eredivisie.
Matthijs de Ligt: Fitoi kampionatin dhe Kupën në Holandë. Arriti në gjysmëfinale të Championsit me Ajaxin. U votua pjesë e skuadrës së sezonit në Eredivisie dhe në Champions League.
Harry Kane: E ndihmoi Tottenhamin të arrinte për herë të parë në histori në finale të Championsit. Shënoi 17 gola ë Premier League në 28 neshje me Spurs. Ishte gjysmëfinalist i Nations League me Anglinë.
Eden Hazard: Fitoi Europa League-n me Chelsea-n. Ishte golashënuesi më i mirë i skuadrës në të gjitha kompeticionet. E votua nga fansat Lojtari i Vitit në Angli.
Sadio Mane: Fitoi Champions League-n me Liverpoolin. Rezultoi golashënuesi më i mirë i Premier League-s me 22 gola (bashkë me Salah dhe Aubameyang). Ndihmoi Senegalin të kualifikohej në finale të Kupës së Kombeve të Afrikës.
Kylian Mbappe: Ndihmoi PSG-në të fitonte titullin e radhës kampion në Francë. Rezultoi golashënuesi më i mirë i PSG-së në të gjitha kompeticionet në sezonin 2018-2019. Është golashënuesi më i ri i Ligue 1 si dhe u shpall lojtari i vitit në Francë.
Lionel Messi: Fitoi titullin e La Ligas me Barcelonën dhe arriti deri në gjysmëfinale të Championsit dhe në finale të Kupës së Mbretit. Fitoi Këpucën e Artë në Europë si golashënuesi më i mirë (kuptohet edhe në La Liga). Ndihmoi Argjentinën të fitonte medaljen e bronztë në Copa America 2019.
Mohamed Salah: Fitues i Champions League-s me Liverpoolin. Golashënuesi më i mirë i skuadrës së Liverpoolit në të gjitha kompeticionet. Golashënuesi më i mirë në Premier League (22 gola bashkë me Mane dhe Aubameyang).
Virgil van Dijk: Fitues i Champions League-s me Liverpoolin. U shpall Lojtari i Vitit në Premier League. Ndihmoi Holandën të kualifikohej në finale të Nations League.
Për femra:
– Lucy Bronze (ING) – Olympique Lione
– Julie Ertz (USA) – Chicago Red Stars
– Caroline Graham Hansen (NOR) – Wolfsburg / FC Barcellona
– Ada Hegerberg (NOR) – Olympique Lione
– Amandine Henry (FRA) – Olympique Lione
– Sam Kerr (AUS) – Chicago Red Stars / Perth Glory
– Rose Lavelle (USA) – Washington Spirit
– Vivianne Miedema (NED) – Arsenal
– Alex Morgan (USA) – Orlando Pride
– Megan Rapinoe (USA) – Reign FC
– Wendie Renard (FRA) – Olympique Lione
– Ellen White (ING) – Birmingham City / Manchester City